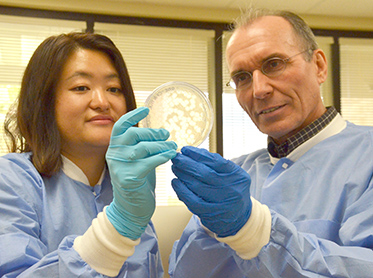
Biotechnology student Daiyuan Zhang and DMC faculty member Rob Hatherill

Vikings are Everywhere!
Del Mar College's strength comes from community involvement and support.
Connection To Our Community

Publications and Pride Points
Annual DMC publications such as Pocket Profile, Points of Pride, and many more.
Get informed!